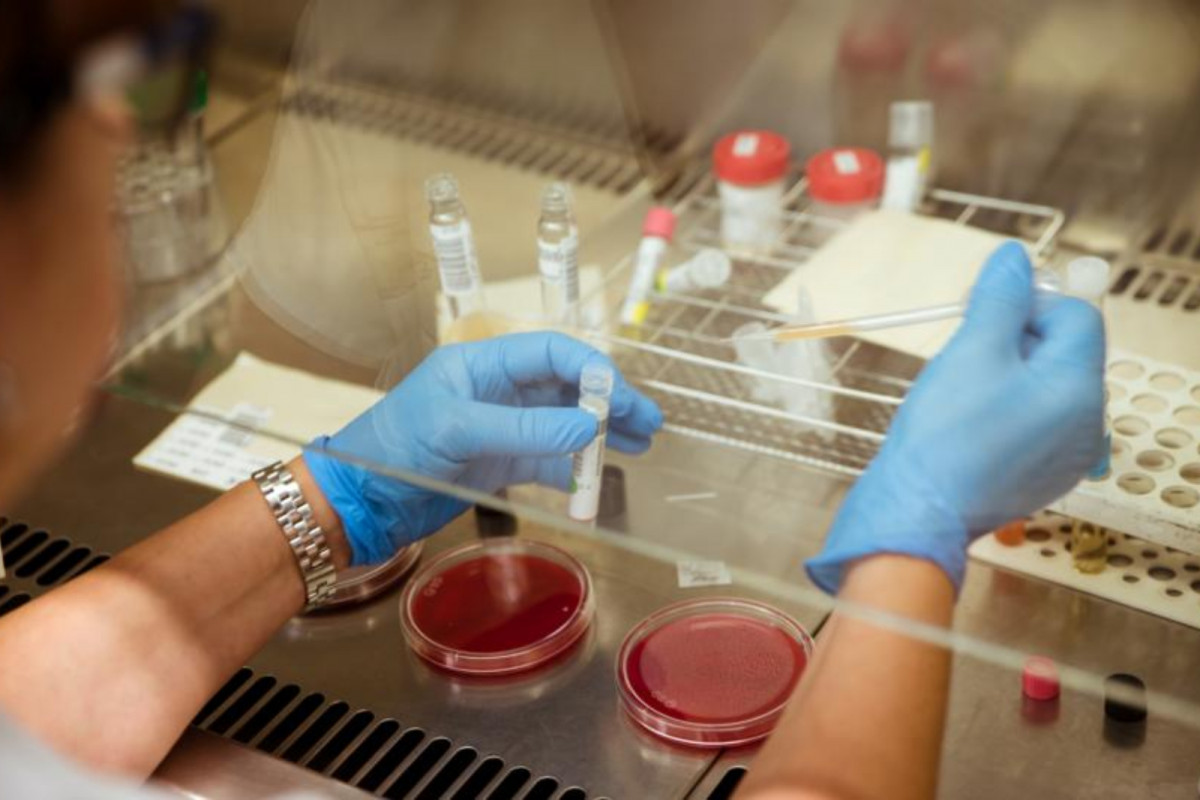

La Fundación La Caixa invertirá 3,4 millones en una treintena de proyectos de biomedicina
Las iniciativas las impulsan varias organizaciones de España y Portugal, ha anunciado el organismo
La Fundación La Caixa destinará 3,4 millones de euros al impulso de 29 proyectos de biomedicina y salud procedentes de centros de investigación, hospitales y universidades de España y Portugal, informa este lunes en un comunicado.
Se trata de los proyectos biomédicos elegidos entre las más de 400 solicitudes recibidas en la convocatoria 2024 del programa CaixaImpulse Innovación, que tiene como objetivo "acelerar" la llegada al mercado de innovaciones biomédicas y acercarlas a los pacientes que las necesiten.
Los 29 seleccionados recibirán, en función del grado de madurez del proyecto, entre 50.000 y 500.000 euros para desarrollarlo en 2 años, y corresponden a diferentes ámbitos de investigación: 12 de ellos a terapias, 9 al diagnóstico, 7 a dispositivos médicos y 1 a la salud digital.
En concreto, algunas de las investigaciones contribuirán al desarrollo de fármacos activados con luz para combatir el dolor crónico, la creación de una prueba diagnóstica rápida de las encefalitis autoinmunes y la validación de una herramienta para predecir el riesgo genético de infarto de miocardio y muerte súbita en jóvenes.
La convocatoria se desarrolla en colaboración con el fondo de inversión de venture capital especializado en biotecnología y ciencias de la salud de CriteriaCaixa, Criteria Bio Ventures, y en partenerariado con la Fundação para a Ciência e a Tecnologia (FCT), del Ministerio de Ciencia, Tecnología y Enseñanza Superior de Portugal.

Escribe tu comentario